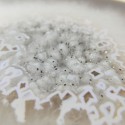
Placa de ágata (460-660gr)

Placa de ágata (460-660gr)
Tamanho aproximado da peça: Variável
Peso aproximado: 460-660gr
Proveniência: Brasil
As peças que serão entregues são semelhantes às que constam das fotografias
A ágata é uma variedade microcristalina do grupo do quartzo, um tipo de calcedónia de várias cores que normalmente apresenta bandas cromáticas. Existem muitos tipos de ágata, a sua cor depende dos diferentes materiais que possa conter. Os mais abundantes são os cinzentos, embora também os possamos encontrar em amarelo, laranja, branco, azul, castanho e rosa.
Por ser um mineral poroso, pode por vezes ser tingido com cores vivas, como no caso da ágata fúcsia, ágata azul profunda ou ágata verde escura.
A ágata no seu estado natural ocorre geralmente como inclusões dentro de cavidades ovóides ou esféricas em rochas vulcânicas. Quando uma bolsa de ágata é aberta, cristalizações de quartzo, ametista ou calcita aparecem normalmente no seu interior.
A sua dureza é de 7 na escala de Mohs e pode ser translúcida ou opaca, dependendo da sua espessura.
Clique aqui para saber mais sobre a ágata.